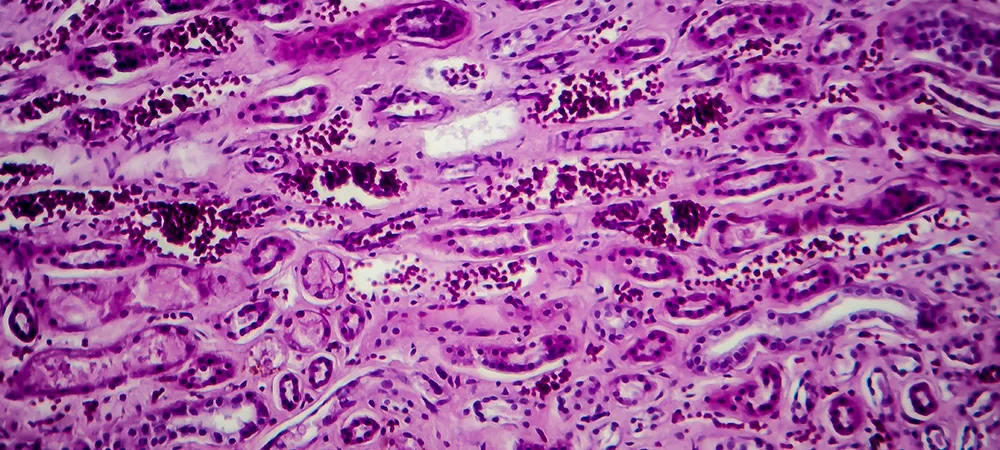
entry image

Proliferatif ne demek? Proliferatif hastalık nedir?
Proliferatif hızla büyüyen ve sayıları artan anlamına gelir. Vücudunuz bir yarası olduğunda yeni hücreler üreterek yarayı onarır, bu normal proliferasyondur. Kanser hücrelerinin kontrolsüzce çoğalması ise anormal proliferasyondur. Proliferatif hastalık ise tek bir tanı değildir; hücrelerin hızla çoğaldığı (proliferasyon gösterdiği) bir hastalığı tanımlayan genel bir terimdir.
Başlıca proliferatif hastalıklar:
Kanser (Malign Proliferasyon)
- En ciddi proliferatif hastalık grubudur
- Hücreler kontrolsüzce çoğalır ve diğer dokulara yayılır
- Akciğer, meme, kolon, prostat kanseri vb.
İyi huylu tümörler (Benign proliferasyon)
- Hücreler çoğalır ancak yayılmaz
- Miyom, lipom, adenom gibi oluşumlar
- Genellikle yaşamı tehdit etmez
Proliferatif retinopati
- Gözde anormal damar çoğalmasıdır
- Diyabet ve orak hücre anemisinde görülür
- Tedavi edilmezse körlüğe yol açabilir
Miyeloproliferatif hastalıklar
- Kemik iliğinde kan hücrelerinin aşırı üretimi
- Polisitemi vera, esansiyel trombositemi, miyelofibrozis
- Lösemiye dönüşme riski taşır
Lenfoproliferatif hastalıklar
- Lenfositlerin (bağışıklık hücreleri) kontrolsüz çoğalması
- Lenfoma, lösemi, multipl miyelom
- Lenf bezleri ve kemik iliğini etkiler
Kronik Myeloid Lösemi (KML)
- Beyaz kan hücrelerinin aşırı üretimi
- Kemik iliğini ve kanı etkiler
Psoriasis (Sedef hastalığı)
- Deri hücrelerinin normalden 10 kat hızlı çoğalması
- Kalın, pullu cilt lezyonlarına yol açar
Endometriozis
- Rahim iç tabakasının rahim dışında çoğalması
- Ağrı ve kısırlığa yol açabilir
Proliferatif ne demek?
Proliferatif, Latince "proles" (döl/nesil) ve "ferre" (taşımak) kelimelerinden türeyen, hızlı çoğalma veya üreme anlamına gelen tıbbi/bilimsel bir terimdir. Hücrelerin veya dokuların hızla çoğaldığı, büyüdüğü veya yayıldığı durumu tanımlar.
Proliferatif hastalık nedir?
Proliferatif hastalık, hücrelerin hızlı, aşırı veya kontrolsüz büyümesi ve bölünmesiyle karakterize edilen, genellikle hücresel matrisin yüksek oranda yenilenmesini içeren tıbbi bir durum olarak tanımlanır. Bu hastalıklar kötü huylu (kanserli) veya iyi huylu (kanserli olmayan ancak büyüyen) olabilir ve kan, deri ve meme dokusu dâhil olmak üzere çeşitli dokuları etkileyebilir.
Tıpta kullanım alanları şu şekildedir:
Proliferatif retinopati
- Gözde anormal damar çoğalmasıyla karakterize bir durum
- Diyabetin ileri evrelerinde görülür
- Diyabetik proliferatif retinopati olarak da bilinir
Proliferatif faz (yara iyileşmesi)
- Yaranın iyileşme sürecindeki hücre çoğalma evresidir
- Yeni doku ve kan damarları oluşur
Proliferatif glomerülonefrit
- Böbrekte hücre çoğalmasıyla seyreden iltihaplanma hastalığı
Proliferatif değişiklik ne anlama gelir?
“Proliferatif değişiklik” tıpta, hücrelerin normalden daha fazla çoğalması (artması) anlamına gelir. Bu durum hücre proliferasyonu ile ilgilidir ve genellikle bir doku incelendiğinde (örneğin biyopsi sonucunda) rapor edilir. Bu ifade tek başına kötü bir şey olduğu anlamına gelmez. Vücuttaki hücreler zaten sürekli yenilenir; yani belirli durumlarda artış normal olabilir. Örneğin hormonlara bağlı değişimler veya iyileşme süreçleri sırasında proliferatif değişiklikler görülebilir.
Ancak bazı durumlarda bu artış, yakından takip edilmesi gereken bir durumu işaret edebilir. Özellikle meme, rahim veya prostat gibi dokularda görüldüğünde, doktorlar bu değişikliğin basit (iyi huylu) mi yoksa atipik (anormal özellikli) mi olduğuna bakar. Atipik proliferatif değişiklikler, ileride kanser gelişme riskini artırabileceği için daha dikkatli izlenir.
Proliferatif hastalıklar tehlikeli midir?
Proliferatif hastalıklar her zaman tehlikeli anlamına gelmez. “Proliferatif” kelimesi, hücrelerin normalden daha hızlı çoğaldığı bir durumu tanımlar, ancak risk, hangi doku veya organın etkilendiğine ve hücrelerin mikroskop altında anormal görünüp görünmediğine bağlıdır. Bazı proliferatif değişiklikleri zararsızdır ve sadece izleme gerektirebilirken, diğerleri daha endişe verici olabilir; özellikle raporda “atipi”, “displazi” veya “karsinoma in situ” veya “invaziv” gibi ifadeler geçiyorsa, bu da kanser öncesi veya kanser olasılığının daha yüksek olduğunu gösterir.





























